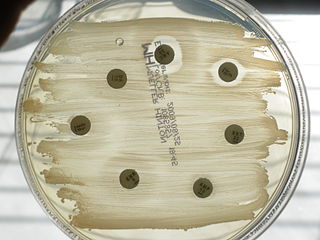
320px-Antibiogram-Mueller-Hinton

Ärzte und Krankenkassen raten Patienten, Vorsorgeuntersuchungen in Anspruch zu nehmen. Aber nicht jede Erkrankung lässt sich sinnvoll anhand von Tests erkennen – und nicht immer profitieren Patienten von Tests. Sind manche Screenings einfach nur unsinnig oder sogar gefährlich? Mehr lesen…

Egal, ob Husten, Schnupfen, Magen-Darmerkrankungen oder kleinere Unfälle: Gegen viele Wehwehchen ist ein Kraut gewachsen. Aber Vorsicht, nicht jede Heilpflanze eignet sich für Kinder. Ihr Apotheker kennt den Unterschied.
Egal, ob Husten, Schnupfen, Magen-Darmerkrankungen oder kleinere Unfälle: Gegen viele Wehwehchen ist ein Kraut gewachsen. Aber Vorsicht, nicht jede Heilpflanze eignet sich für Kinder. Ihr Apotheker kennt den Unterschied. 